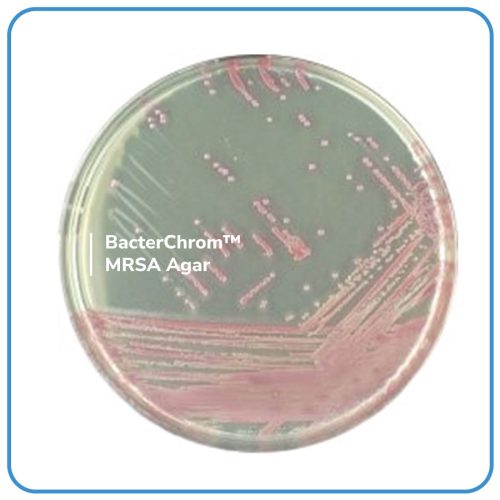
BacterChrom™ MRSA Agar

BacterChrom™ MRSA Agar là môi trường chromogenic chọn lọc và phân biệt được thiết kế để phát hiện định tính trực tiếp sự hiện diện của MRSA, hỗ trợ ngăn ngừa và kiểm soát MRSA trong các cơ sở y tế.
Mã: 4101016
| Tên sản phẩm | Hình ảnh | Mã đặt hàng/sản phẩm | Đơn vị tính | Số lượng | Chọn vào giỏ hàng |
|---|---|---|---|---|---|
| BacterChrom™ MRSA Agar | ![]() | 4101016 | Đĩa |